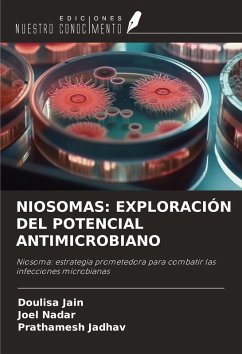

Química y potencial antimicrobiano de las tienopirimidinonas
Farmacología de los nuevos derivados de la tienopirimidinona
Versandkostenfrei!
Versandfertig in 1-2 Wochen
36,99 €
inkl. MwSt.

PAYBACK Punkte
18 °P sammeln!
Las tienopirimidinonas son el bioéster de los heterocíclicos de quinazolina y, a diferencia de la quinazolina, existen tres posibles anulaciones del tiofeno en el anillo de pirimidina: la tieno[2,3-d] pirimidina, la tieno[3,2-d]pirimidina y la tieno[3,4-d]pirimidina. La fracción de las tienopirimidinonas presenta diversas actividades como analgésica, antihipertensiva, inhibidora de la agregación plaquetaria, antiprotozoaria, broncodilatadora, inhibidora de la fosfodiesterasa y antihistamínica. Se ha evaluado la actividad antimicrobiana de algunos derivados novedosos de las tienopirimidin...
Las tienopirimidinonas son el bioéster de los heterocíclicos de quinazolina y, a diferencia de la quinazolina, existen tres posibles anulaciones del tiofeno en el anillo de pirimidina: la tieno[2,3-d] pirimidina, la tieno[3,2-d]pirimidina y la tieno[3,4-d]pirimidina. La fracción de las tienopirimidinonas presenta diversas actividades como analgésica, antihipertensiva, inhibidora de la agregación plaquetaria, antiprotozoaria, broncodilatadora, inhibidora de la fosfodiesterasa y antihistamínica. Se ha evaluado la actividad antimicrobiana de algunos derivados novedosos de las tienopirimidinonas según el protocolo estándar y se ha comprobado que todos los derivados son igual de potentes que un fármaco estándar.